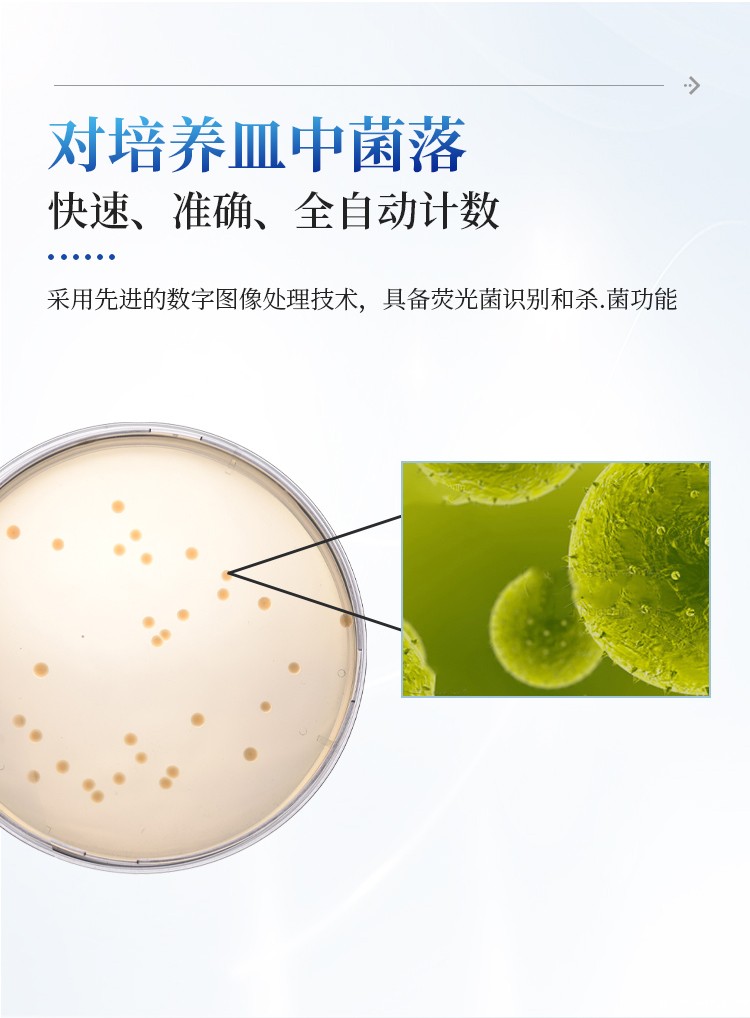

简要描述: 菌落总数快速检测仪是一款集图像采集、数据处理与统计于一体的自动菌落计数,广泛应用于食品、药品、化妆品、环境监测、医疗卫生、科研院校等领域的菌落计数。该仪器采用先进的数字图像处理技术,具备荧光菌识别和杀菌功能,可实现对培养皿中菌落的快速、准确、全自动计数,显著提升实验效率,降低人工误差。
产品型号:
IN-J500
访问量:
3
| 一、产品介绍: |
本产品是一款集图像采集、数据处理与统计于一体的自动菌落计数,广泛应用于食品、药品、化妆品、环境监测、医疗卫生、科研院校等领域的菌落计数。该仪器采用先进的数字图像处理技术,具备荧光菌识别和杀菌功能,可实现对培养皿中菌落的快速、准确、全自动计数,显著提升实验效率,降低人工误差。
| 二、性能指标 |
1、成像装置
全封闭暗箱,能够消除外环境杂散光干扰
三色LED可见光
内置254nm紫外灯,可对腔体杀菌消毒、诱变
内置366nm紫外灯,可激发菌落荧光,满足大肠埃希氏菌计数、绿色荧光蛋白观察等需求
★可通过软件自由调节上、下光源亮度、开启关闭
★光源强度自由调节,光源方案可保存,可直接调用历史方案
2000万像素超清彩色相机
1200万像素12mm高清镜头
★可检测最小菌落:0.04mm
★计数精度:≥98%
★计数时间:1200CFU/S
平皿类型:倾注、涂布、膜滤、3M 纸片
适合培养皿的直径:标准的90-100mm(其他小号培养皿放置光圈中央)
2、软件功能
1) 10种模式分类一键计数:
分散菌一键计数:对边缘比较清晰,分布较为分散的菌落进行快速统计
黏连菌一键计数:适用于背景颜色单一、菌落黏连边缘模糊的菌落快速统计
微小菌一键计数:适用于直径0.1mm-0.5mm的微小菌落的快速统计
大菌落一键计数:适用于直径大于2mm的微小菌落的快速统计
3M(PetriFilm)一键计数:对生长在3M纸片上的菌落进行快速统计
黑色网格(Compact Dry)一键计数:对生长在黑色实线纸片上的菌落进行快速统计
网格滤膜(RIDA)一键计数:对生长在滤膜纸片上的菌落进行快速统计
背景相近菌一键计数:适用于菌落颜色与培养基颜色相近的菌落进行快速统计
单色菌一键计数:单色菌落、多色菌落选中一种颜色进行快速统计
多色菌一键计数:可多次单击目标菌落,自动提取对应颜色,即可自动分割出所选区域内所有相同颜色菌落,适用于多色菌中特定颜色菌落的统计
2) 辅助统计工具
人工修正:鼠标双击可添加或删除遗漏菌落;框选添加或删除遗漏菌落
智能修正:在一键统计基础上可进行智能修正
测量工具:角度、线段、面积、曲线
污染菌(杂质)剔除:根据颜色、直径、圆度剔除杂质
单菌落形态分析:点击单个菌落,可得知这个菌落的圆度、直径、周长、面积等信息
所有菌落形态:统计完后可得知平板上所有菌落的圆度、直径、周长、面积等信息
菌落大小分类:统计完后,根据每个菌落轮廓大小,按25档分类显示
样本菌落总数换算:根据实际培养皿直径、样本稀释度,实现自动换算
3、数据安全与管理
多用户登录系统,每个账户形成独立数据,数据长久保存
统计结果以PDF格式输出,原始数据不可更改
具备审计追踪功能,操作人员在软件上的每一步操作软件自动记录,以便后续结果数据的追溯
4、光源管理
该系列全自动菌落计数仪配备了灵活的上、下双光源系统,用户可以根据不同培养皿的类型、菌落特性以及背景情况,用软件自由调节光源以获得最佳的成像效果。
具体功能包括:
独立控制:上光源和下光源可以单独开启或关闭。
★亮度调节:可直接在软件上实现每个光源亮度的自由调节,微调,以适应不同对比度的需求。
模式切换:用户可以在“仅上光”、“仅下光”、“上下光同时开启”等多种照明模式间自由切换。
★方案保存:用户可以将自己设置好的光源组合(包括开关状态和亮度)保存为自定义方案。当再次遇到相同类型的样本时,可直接调用该方案,无需重复设置,极大地提高了工作效率和结果的一致性。
5、标定功能
为确保测量结果的精确性,本系列全自动菌落计数仪提供可靠的尺寸标定功能,将图像上的像素单位转换为实际的物理尺寸(如毫米),从而保证菌落直径、面积等测量数据的准确性。该功能分为自动标定和手动标定两种模式,以满足不同用户和场景的需求。